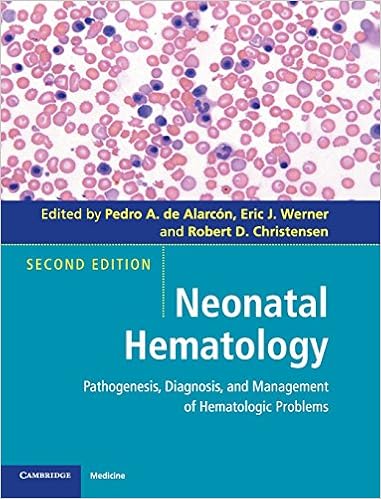
Neonatal Hematology Pathogenesis Diagnosis And Management -

Delivery Technologies For Cancer Immunotherapy Nature
Delivery Technologies For Cancer Immunotherapy Nature

Treatment Strategies Oncology Volume 1 Issue 1
 Postgraduate Haematology 0001405191805 Medicine Health
Postgraduate Haematology 0001405191805 Medicine Health
 Dyskeratosis Congenita Molecular Insights Into Telomerase
Dyskeratosis Congenita Molecular Insights Into Telomerase
 Journal Of Oncology Pharmacy Practice Volume 25 Number 7
Journal Of Oncology Pharmacy Practice Volume 25 Number 7
 Comprehensive Genomic Analysis Of Rhabdomyosarcoma Reveals A
Comprehensive Genomic Analysis Of Rhabdomyosarcoma Reveals A
 Cambridge Medical Reviews Haematological Oncology Volume 4
Cambridge Medical Reviews Haematological Oncology Volume 4
 Why Does Inflammation Persist A Dominant Role For The
Why Does Inflammation Persist A Dominant Role For The

Tp53 Aberrations In Chronic Lymphocytic Leukemia An
 Diagnosis Of Cancer As An Emergency A Critical Review Of
Diagnosis Of Cancer As An Emergency A Critical Review Of
 Pdf New Approaches To Target T All
Pdf New Approaches To Target T All
 Genomic Heterogeneity As A Barrier To Precision Medicine In
Genomic Heterogeneity As A Barrier To Precision Medicine In
 Molecular Oncology Causes Of Cancer And Targets For
Molecular Oncology Causes Of Cancer And Targets For
Atrius Health
Neonatal Hematology Pathogenesis Diagnosis And Management
Neonatal Hematology Pathogenesis Diagnosis And Management
